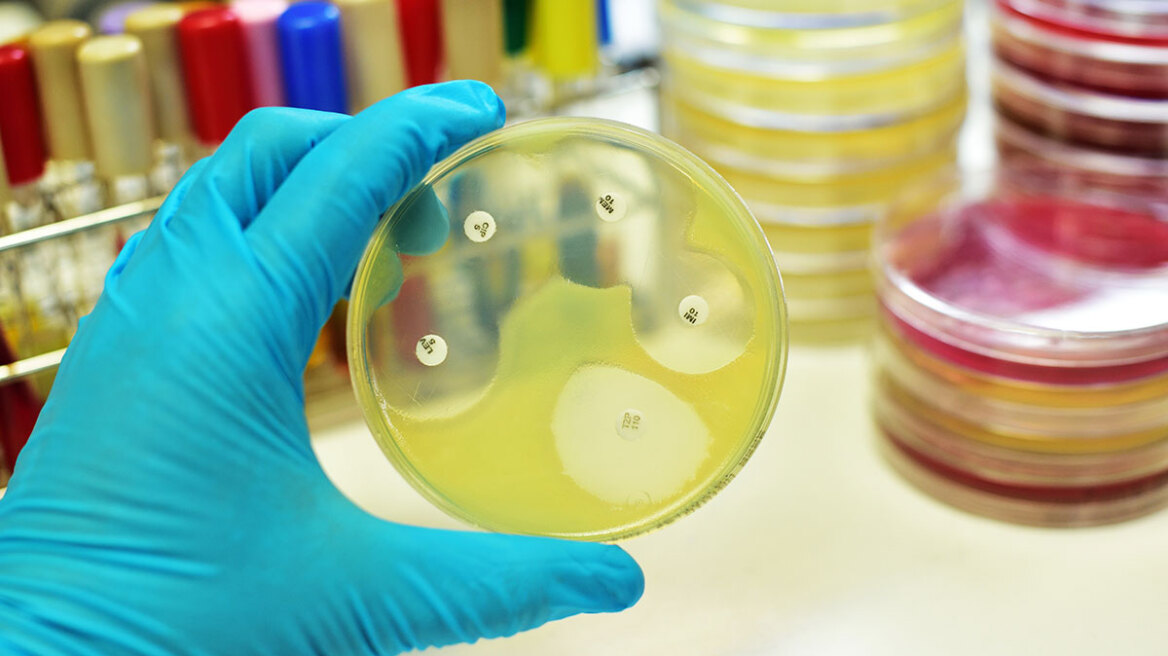
Κορωνοϊός - Κίνα: Απαντά σε ΗΠΑ και FBI για τις κατηγορίες περί υποκλοπών

Η Κίνα κατηγόρησε σήμερα τις ΗΠΑ ότι τη «δυσφημούν», αφού η Ουάσινγκτον χθες κατηγόρησε το Πεκίνο ότι προσπαθεί να κλέψει τις αμερικανικές έρευνες για την ανάπτυξη εμβολίου
κατά του κορωνοϊού.
Την Τετάρτη το
FBI κατηγόρησε χάκερ, ερευνητές και φοιτητές που πρόσκεινται στην Κίνα ότι υποκλέπτουν πληροφορίες από αμερικανικά ινστιτούτα και εργαστήρια για λογαριασμό του Πεκίνου.
«Οι απόπειρες της Κίνας να στοχοθετήσει αυτούς τους τομείς αποτελεί σοβαρή απειλή για την απάντηση της χώρας μας στην covid-19», ανέφερε η αμερικανική ομοσπονδιακή αστυνομία σε επίσημη προειδοποίηση που εξέδωσε από κοινού με την εθνική υπηρεσία κυβερνοασφάλειας.
«Η Κίνα εκφράζει την έντονη δυσαρέσκειά της και την έντονη αντίθεσή της στην αμερικανική δυσφήμηση», απάντησε σήμερα ο
Ζάο Λιζιάν, εκπρόσωπος του κινεζικού υπουργείο Εξωτερικών.
Οι νέες κατηγορίες της κυβέρνησης του προέδρου
Ντόναλντ Τραμπ επιδεινώνουν τις ήδη τεταμένες σχέσεις μεταξύ ΗΠΑ και Κίνας αναφορικά με την covid-19.
«Κρίνοντας από το παρελθόν τους, οι ΗΠΑ είναι αυτές που διεξάγουν τις μεγαλύτερες επιχειρήσεις κλοπής στο διαδίκτυο σε παγκόσμιο επίπεδο», πρόσθεσε ο Ζάο.
Πολλές κινεζικές φαρμακευτικές εταιρείες έχουν ξεκινήσει από την αρχή της επιδημίας του κορωνοϊού να εργάζονται για την ανάπτυξη εμβολίου. Για τουλάχιστον τρία εμβόλια έχουν ξεκινήσει κλινικά τεστ σε ανθρώπους.
«Η Κίνα βρίσκεται στο σημείο αιχμής σε ό,τι αφορά την έρευνα για εμβόλια και θεραπεία κατά της covid-19», υπογράμμισε ο εκπρόσωπος του κινεζικού υπουργείου.
Εδώ και εβδομάδες ο Τραμπ κατηγορεί την Κίνα ότι απέκρυψε τις διαστάσεις της επιδημίας, που εμφανίστηκε για πρώτη φορά τον Δεκέμβριο του 2019 στην πόλη Ουχάν, γεγονός που επέτρεψε τη μεγάλη εξάπλωσή της σε όλο τον κόσμο.
Το Πεκίνο αρνείται τις κατηγορίες αυτές και τονίζει ότι ενημέρωσε το συντομότερο δυνατό τον
Παγκόσμιο Οργανισμό Υγείας και άλλες χώρες, ανάμεσα στις οποίες και οι ΗΠΑ, για τις πληροφορίες που διέθετε.
Ειδήσεις σήμερα:
Η CIA βάζει φωτιά στον «πόλεμο» Κίνας-ΗΠΑ: Το Πεκίνο μάζεψε 56 εκατ. μάσκες και αναπνευστήρες ενώ «έκρυβε» τον κορωνοϊό
Ένα λεπτό ομιλίας γεννά πάνω από 1.000 σταγονίδια με κορωνοϊό - Μένουν στον αέρα τουλαχιστον οκτώ λεπτά
Το lockdown αύξησε τους... γυμνιστές στη Βρετανία